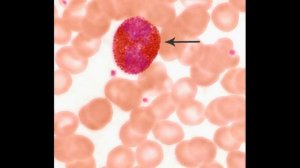
Мазок крови человека. Гистологический препарат

5:14
5:14
2021-09-17 09:00

 12:27
12:27
12:27
12:27
2023-11-16 22:31

 16:19
16:19

 16:19
16:19
2024-12-23 13:19

 14:37
14:37

 14:37
14:37
2023-11-17 21:54

 14:02
14:02

 14:02
14:02
2023-11-24 20:29

 3:02
3:02

 3:02
3:02
2023-09-24 01:20

 9:36
9:36

 9:36
9:36
2025-01-23 02:11

 16:23
16:23

 16:23
16:23
2024-12-18 13:22

 55:30
55:30

 55:30
55:30
2025-02-12 12:09

 1:35:10
1:35:10

 1:35:10
1:35:10
2024-01-02 23:03

 3:22
3:22

 3:22
3:22
2025-07-09 12:59

 22:38
22:38

 22:38
22:38
2018-07-17 05:18

 4:30
4:30

 4:30
4:30
2022-03-29 10:15

 3:01
3:01

 3:01
3:01
2026-01-11 15:17

 5:19
5:19

 5:19
5:19
2025-06-13 15:56

 7:59
7:59

 7:59
7:59
2026-02-17 08:10

 5:31
5:31

 5:31
5:31
2025-12-06 22:46

 6:24
6:24
![Сухроббек Йулдошев - Истанбул (Премьера клипа 2026)]() 3:00
3:00
![ПЛУТТО, AELITA AZINA - Не для меня (Премьера клипа 2026)]() 2:06
2:06
![Дана Лахова - Ночь, ночь (Премьера клипа 2026)]() 3:01
3:01
![Эльдар Агачев - Догорает костер (Премьера клипа 2026)]() 2:23
2:23
![Liana Lee - Глаза-магнит (Премьера клипа 2026)]() 2:01
2:01
![Шамиль Каримов - Танцуй малая (Премьера клипа 2026)]() 3:33
3:33
![Elvira T - Одинокая пантера (Премьера клипа 2026)]() 2:08
2:08
![Enrasta - Не для меня (Премьера клипа 2026)]() 3:38
3:38
![DOMENICA - PINOKIO (Премьера клипа 2026)]() 3:23
3:23
![Аюбхон Усмонов - Асал (Премьера клипа 2026)]() 3:28
3:28
![Тон Дуэт - Время (Премьера клипа 2026)]() 3:36
3:36
![Самир Санаев - Асролмадик (Премьера клипа 2026)]() 4:04
4:04
![Максим АРШАВИН - Горько (Премьера клипа 2026)]() 3:09
3:09
![Гузэлем - Рамазан (Премьера клипа 2026)]() 2:45
2:45
![MeMaria - Абсолютно всё (Премьера клипа 2026)]() 2:52
2:52
![NILETTO, Татьяна Буланова - Первыми (Премьера клипа 2026)]() 2:52
2:52
![Жалолиддин Ахмадалиев - Ёлгон дунё (Премьера клипа 2026)]() 3:44
3:44
![Zamina Elman - Ты полюбила хулигана (Премьера клипа 2026)]() 2:34
2:34
![Артур Халатов - Не моя (Премьера клипа 2026)]() 3:28
3:28
![Вика Ветер - Ты не забывай меня (Премьера клипа 2026)]() 3:57
3:57
![Дикий робот | The Wild Robot (2024)]() 1:41:50
1:41:50
![Миссия невыполнима: Финальная расплата | Mission: Impossible - The Final Reckoning (2025)]() 2:52:58
2:52:58
![Орудия | Weapons (2025)]() 2:08:34
2:08:34
![Новокаин | Novocaine (2025)]() 1:49:34
1:49:34
![Давид | David (2025)]() 1:49:18
1:49:18
![Игры Биста. 2 сезон, 5 серия | Beast Games 2 season]() 49:20
49:20
![Кровь на границе | Frontier Crucible (2025)]() 2:04:36
2:04:36
![Возвращение в Сайлент Хилл | Return to Silent Hill (2026)]() 1:45:30
1:45:30
![Элементарно | Elemental (2023)]() 1:41:31
1:41:31
![Лакомый кусок | The Rip (2025)]() 1:52:50
1:52:50
![Одинокие волки | Wolfs (2024)]() 1:47:12
1:47:12
![Иерархия | Hierarchy (2025)]() 1:39:35
1:39:35
![Миссия невыполнима: Смертельная расплата | Mission: Impossible - Dead Reckoning (2023)]() 2:46:48
2:46:48
![Зомби по имени Шон | Shaun of the Dead (2004)]() 1:39:31
1:39:31
![Лило и Стич | Lilo & Stitch (2025)]() 1:49:28
1:49:28
![Пойман с поличным | Caught Stealing (2025)]() 1:46:45
1:46:45
![Игры Биста. 2 сезон, 6 серия | Beast Games 2 season]() 1:01:28
1:01:28
![Отпуск на двоих | People We Meet on Vacation (2026)]() 1:57:55
1:57:55
![Точка замерзания | Dead of Winter (2025)]() 1:37:45
1:37:45
![Элла Маккей | Ella McCay (2025)]() 1:54:47
1:54:47
![Команда Дино Сезон 2]() 12:31
12:31
![Шахерезада. Нерассказанные истории Сезон 1]() 23:53
23:53
![Рэй и пожарный патруль Сезон 1]() 13:27
13:27
![Агент 203]() 21:08
21:08
![Приключения Тайо]() 12:50
12:50
![Паровозик Титипо]() 13:42
13:42
![Панда и петушок Лука]() 12:12
12:12
![Неодети]() 11:27
11:27
![Команда Дино. Исследователи Сезон 2]() 13:26
13:26
![Умка]() 7:11
7:11
![Зебра в клеточку]() 6:30
6:30
![Кадеты Баданаму Сезон 1]() 11:50
11:50
![МиниФорс]() 0:00
0:00
![Пингвиненок Пороро]() 7:42
7:42
![Новое ПРОСТОКВАШИНО]() 6:30
6:30
![Приключения Пети и Волка]() 11:00
11:00
![Последний книжный магазин]() 11:20
11:20
![Зомби Дамб]() 5:14
5:14
![Сборники «Оранжевая корова»]() 1:05:01
1:05:01
![Врумиз. 1 сезон]() 13:10
13:10
![Аватар: Путь воды (2022)]() 3:12:39
3:12:39
![_*ДискотекА 80-90х ВиДео АлЬбом Лучшие.*_]() 2:40:60
2:40:60
![Антиреспект - Тишины хочу]() 4:33
4:33
![Штрафбат(1-11 серии) HD 2004]() 8:05:56
8:05:56
![Бандитский Петербург. Все серии подряд. 60fps]() 66:54:01
66:54:01
![Сборник Новогодних Номеров 2024 - Уральские Пельмени]() 3:18:51
3:18:51
![50 клипов шансона]() 3:12:53
3:12:53
![Зверополис 2 | Zootopia 2 (2025)]() 1:47:36
1:47:36
![СваТы 1 сезон(все серии)]() 2:17:36
2:17:36
![Bakhtin - Целовала (Премьера клипа 2023)]() 3:16
3:16
![28 лет спустя: Часть II. Храм костей | 28 Years Later: The Bone Temple (2026)]() 1:49:24
1:49:24
![Jazzdauren - Дарите женщинам цветы]() 3:09
3:09
![КЛИПЫ 90х ⭐Русский Сборник видеоклипов]() 2:54:39
2:54:39
![Дьявол носит Prada | The Devil Wears Prada (2006)]() 1:49:29
1:49:29
![Премьера: Предательство - фильм Андрея Медведева от 01.02.2026]() 59:17
59:17
![Аватар 3: Пламя и пепел фильм, 2025]() 3:09:06
3:09:06
![ANNA ASTI - ЦАРИЦА ( Премьера клипа 2023 )]() 4:01
4:01
![Давид | David (2025)]() 1:49:18
1:49:18
![Лунтик | Танцы 💃💃💃 Сборник мультиков для детей]() 46:30
46:30
![ТОП ЛУЧШИХ КЛИПОВ ШАНСОНА - Слушать шансон лучшее.]() 3:48:45
3:48:45

 6:24
6:24Скачать Видео с Рутуба / RuTube
| 256x144 | ||
| 640x360 | ||
| 1280x720 | ||
| 1920x1080 |
 3:00
3:00
2026-02-14 12:40
 2:06
2:06
2026-02-13 17:35
 3:01
3:01
2026-02-17 09:46
 2:23
2:23
2026-02-16 19:36
 2:01
2:01
2026-02-19 13:26
 3:33
3:33
2026-02-19 13:20
 2:08
2:08
2026-02-23 13:25
 3:38
3:38
2026-02-18 17:15
 3:23
3:23
2026-02-24 11:00
 3:28
3:28
2026-02-25 09:33
 3:36
3:36
2026-02-18 12:03
 4:04
4:04
2026-02-14 12:36
 3:09
3:09
2026-02-20 23:46
 2:45
2:45
2026-02-19 13:22
 2:52
2:52
2026-02-13 18:08
 2:52
2:52
2026-02-13 17:37
 3:44
3:44
2026-02-22 22:48
 2:34
2:34
2026-02-25 09:32
 3:28
3:28
2026-02-16 17:48
 3:57
3:57
2026-02-20 09:52
0/0
 1:41:50
1:41:50
2026-01-23 18:44
 2:52:58
2:52:58
2026-01-23 19:12
 2:08:34
2:08:34
2026-01-23 18:44
 1:49:34
1:49:34
2026-01-23 18:44
 1:49:18
1:49:18
2026-01-29 11:25
 49:20
49:20
2026-01-23 13:36
 2:04:36
2:04:36
2026-01-26 14:34
 1:45:30
1:45:30
2026-02-24 21:57
 1:41:31
1:41:31
2026-01-23 18:43
 1:52:50
1:52:50
2026-02-04 10:11
 1:47:12
1:47:12
2026-01-23 18:43
 1:39:35
1:39:35
2026-02-06 18:40
 2:46:48
2:46:48
2026-01-23 18:43
 1:39:31
1:39:31
2026-02-16 01:07
 1:49:28
1:49:28
2026-01-23 18:44
 1:46:45
1:46:45
2026-01-19 12:39
 1:01:28
1:01:28
2026-02-04 10:24
 1:57:55
1:57:55
2026-01-14 15:48
 1:37:45
1:37:45
2026-01-26 14:35
 1:54:47
1:54:47
2026-02-11 21:47
0/0
2021-09-22 22:40
2021-09-22 23:25
2021-09-22 23:51
 21:08
21:08
2025-01-09 16:39
 12:50
12:50
2024-12-17 13:25
 13:42
13:42
2024-11-28 14:12
 12:12
12:12
2024-11-29 14:21
 11:27
11:27
2025-10-10 18:25
2021-09-22 22:54
 7:11
7:11
2026-01-20 10:00
 6:30
6:30
2022-03-31 13:09
2021-09-22 21:17
 0:00
0:00
2026-02-26 00:15
 7:42
7:42
2024-12-17 12:21
 6:30
6:30
2018-04-03 10:35
 11:00
11:00
2022-04-01 17:59
 11:20
11:20
2025-09-12 10:05
 5:14
5:14
2024-11-28 13:12
 1:05:01
1:05:01
2025-12-12 12:24
2021-09-24 16:00
0/0
Скачать популярное видео
Популярное видео
2025-06-17 19:00
2024-03-18 17:25
 4:33
4:33
2019-12-02 21:15
 8:05:56
8:05:56
2017-07-08 19:33
2023-05-15 17:30
2024-12-31 14:00
2022-12-22 16:10
 1:47:36
1:47:36
2025-12-25 17:49
 2:17:36
2:17:36
2025-07-24 20:55
 3:16
3:16
2023-10-13 14:26
 1:49:24
1:49:24
2026-02-19 14:08
 3:09
3:09
2024-05-30 14:13
2022-03-11 11:17
 1:49:29
1:49:29
2023-04-27 15:40
 59:17
59:17
2026-02-01 14:02
2025-12-26 16:56
 4:01
4:01
2023-10-12 11:54
 1:49:18
1:49:18
2026-01-29 11:25
2024-08-05 22:22
2026-02-02 14:57
0/0

